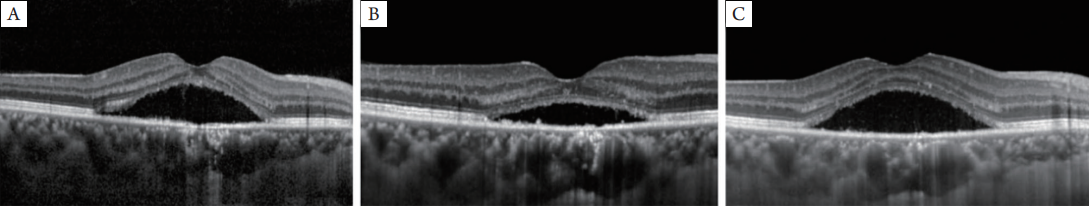

4例具有挑战性且不寻常的视网膜病例临床精粹讨论
阅读量:3316
DOI:doi: 10.3978/j.issn.1000-4432.2017.10.02
发布日期:2024-12-08
作者:
Yongsheng Huang ,Lijun Zhou ,Yuxin Yuan ,Xiling Yu ,Zhengjie Xu ,Jie Hu ,Tao Li ,Lin Lu ,Chenjin Jin
展开更多 '%20fill='white'%20fill-opacity='0.01'/%3e%3cmask%20id='mask0_3477_29692'%20style='mask-type:luminance'%20maskUnits='userSpaceOnUse'%20x='0'%20y='0'%20width='16'%20height='16'%3e%3crect%20id='&%23232;&%23146;&%23153;&%23231;&%23137;&%23136;_2'%20x='16'%20width='16'%20height='16'%20transform='rotate(90%2016%200)'%20fill='white'/%3e%3c/mask%3e%3cg%20mask='url(%23mask0_3477_29692)'%3e%3cpath%20id='&%23232;&%23183;&%23175;&%23229;&%23190;&%23132;'%20d='M14%205L8%2011L2%205'%20stroke='%23333333'%20stroke-width='1.5'%20stroke-linecap='round'%20stroke-linejoin='round'/%3e%3c/g%3e%3c/g%3e%3c/svg%3e)
关键词
讨论
视网膜疾病病例
摘要
3位国际视网膜专家在中山眼科中心(Zhongshan Ophthalmic Center,ZOC)眼底病中心进行临床查房并讨论了4例具有挑战性且不寻常的视网膜病例:1)VHL病合并视网膜血管母细胞瘤的11年
随访观察;2)半剂量光动力疗法(photodynamic therapy,PDT)或微脉冲激光光凝治疗中心性浆液性视网膜病变(central serous chorioretinopathy,CSC)的观察;3)视神经缺陷儿童的诊断与治疗;4)合并虹膜晶状体脉络膜缺损的视网膜脱离(retinal detachment,RD)的治疗选择。通过讨论有助于我们更好地了解这四例视网膜疾病的发病机制和治疗方法,及其与全身疾病的关系。
全文
2016年6月16日,中山眼科中心(Zhong shan
Ophthalmic Center,ZOC)视网膜医学和流行病学研讨会的前1天,Emily Y.Chew,Robert P.Murphy和Timothy W.Olsen,3位国际知名的视网膜专家,会同国际著名眼科病理学家Chi-Chao Chan,应邀参加了ZOC眼底病中心的视网膜临床查房。查房期间,对4例具有挑战性的且不寻常的视网膜病例进行了介绍和讨论。以下总结了来自这4个病例的临床精粹。
1 病例报告和病例讨论
1.1 病例一
1.1.1 病例介绍
11年前,即2005年,一位患有家族性von
Hippel-Lindau (VHL)病的20岁女性,主诉左眼视
力逐渐下降和上方视野缺损6个月。她在第一次来ZOC时没有全身症状。她的父亲患有双眼视网膜
血管母细胞瘤;她的叔叔和姑妈均有小脑血管母细胞瘤的病史。她的视力右眼为1.2(20/16),左眼为0.4(20/50)。双眼前段正常。在右眼鼻上周边部视网膜可见小视网膜血管母细胞瘤(图1)。在左眼鼻侧和下方周边部视网膜可看到3个大视网膜血管母细胞瘤且伴有扩张的滋养血管,其周围有渗出性视网膜脱离以及多处硬性和软性渗出(图2),在周边部可注意到一些微小的视网膜血管母细胞瘤。在下方周边部可见牵拉性和渗出性视网膜脱离(retinal detachment,RD)同时伴有黄斑水肿。对双眼较小的视网膜血管母细胞瘤进行激光光凝治疗。后来,患者成功接受左眼玻璃体切除术(pars
plana vitrectomy,PPV),进行了鼻侧最大的视网膜血管母细胞瘤切除、眼内光凝、眼内电凝术及硅油填充治疗。术后3个月,左眼可观察到平整的视网膜和鼻部视网膜血管母细胞瘤的切除部位
(图3 )。不幸的是,由于在下方视网膜前膜形成和复发性RD,患者黄斑持续水肿,并且在术后
6个月,她的视力减退逐渐加重。左眼接受PPV后
2年,进行了白内障手术治疗,然而硅油仍存留在眼内。11年后,在最近的随访中,发现她的右眼视力为1.2(20/16),左眼为光感。右眼眼前段正常,眼底未发现新的视网膜母细胞瘤,激光光凝术后的视网膜血管母细胞瘤表现为局部萎缩灶(图4)。但在左眼,晶状体后囊混浊,在视网膜下方周边部可见黄斑前膜和RD。长期的随访过程中,发现某些全身性疾病的进展。2012年发现左肾囊肿,并行微创手术治疗。2013年确诊为小脑血管母细胞瘤,但该病变体积小且稳定,目前仍在观察。





图1 眼底照片显示右眼鼻上方周边部可见细小的视网膜血管母细胞瘤(箭头)

图2 眼底照片显示左眼鼻侧和下方周边部可见3个大的视网膜血管母细胞瘤(箭头),伴有扩张的滋养血管及周围浆液性脱离和渗出

图3 眼底照片显示平整的视网膜和鼻侧视网膜血管母细胞瘤的切除部位

图4 眼底照片显示右眼视网膜血管母细胞瘤(箭头)经激光光凝术后局部萎缩
1.1.2 病例讨论
所有的视网膜专家一致认为,病例1为VHL病合并视网膜血管母细胞瘤的典型病例。该罕见病的专家Chew教授表示:视网膜和中枢神经系统(central nerve system,CNS)的血管母细胞瘤是最常见的表现,并且往往是VHL病的早期表现[1]。她建议,激光光凝治疗可彻底治疗如本例患者的较小的视网膜母细胞瘤[2]。Xiaoling Liang教授是该患者的主治医生,Chenjin Jin教授是激光治疗专家,他们提出VHL病合并视网膜血管母细胞瘤的治疗技术和经验。
Chan教授[3-4]提到:大血管母细胞瘤可采用放射贴敷治疗或手术切除视网膜血管瘤瘤体而治疗成功,但在中国,目前放射贴敷治疗还无法应用;因此,对于激光和冷冻治疗无效的较大的视网膜血管母细胞瘤,手术切除是治疗的首选。Olsen教授认为:这例中采用PPV手术切除大的视网膜血管母细胞瘤是一个具有挑战性的过程。虽然长期随访中会出现白内障和复发性RD,但是手术延长了患者左眼视觉质量时间。由于VHL病是
一种多系统肿瘤综合征,Murphy教授[5] 强调了全身医学观察的重要性。所有的视网膜专家一致认为,病例1为VHL病合并视网膜血管母细胞瘤的典型病例。该罕见病的专家Chew教授表示:视网膜和中枢神经系统(central nerve system,CNS)的血管母细胞瘤是最常见的表现,并且往往是VHL病的早期表现[1]。她建议,激光光凝治疗可彻底治疗如本例患者的较小的视网膜母细胞瘤[2]。Xiaoling Liang教授是该患者的主治医生,Chenjin Jin教授是激光治疗专家,他们提出VHL病合并视网膜血管母细胞瘤的治疗技术和经验。
1.2 病例二
1.2.1 病例介绍
一 位前来ZOC的41岁男性患者,主诉右眼视力下降6个月。在当地医院进行中医治疗后视力没有改善。没有其他眼部疾病或系统性疾病史。最佳矫正视力(best corrected
visual acuity,BC VA )右眼0.5(20 / 40),左眼1.0 (20 / 20)。双眼眼压正常,眼前段没有异常发现。在右眼黄斑区可见视网膜神经上皮层的浆液性脱离和色素改变,眼底荧光血管造影(fundus fluores cence ang iography,FFA)表现为黄斑中心凹附近的局灶性渗漏(图5)。黄斑光学相干断层成像(optical coherencetomography,OCT)可见视网膜下积液(subretina l fluid,SRF)伴小灰白色视网膜下沉积物,以及粗糙的视网膜色素上皮细胞(retinal pigment epithelium,RPE)层(图6)。基于上述检查,右眼被诊断为慢性中心性浆液性视网膜病变(central serous
chorioretinopathy,CSC)。右眼进行的半剂量光动力疗法(photodynamic therapy,PDT)是患者在获得知情同意后进行的。然而,在治疗后1,3和6个月的随访中发现持续的SRF(图7)。视力保持在0.5(20/40)。同时,黄斑敏感性逐渐下降。
此时,我们建议患者采取第二次半剂量PDT。但该患者由于经济原因拒绝此建议,而接受阈下微脉冲激光光凝(subthreshold micropulse laser
photocoagulation,SMLP)治疗。SMLP的参数如
下:模式,微脉冲模式;占空比,5%;曝光时间200 ms;激光光斑,100 μm;功率675 MW(滴
定功率的50%)。SMLP治疗3个月后,OCT图像显示SRF完全吸收(图8),并且黄斑敏感性从14.6提高至25.6 dB(图9),视力提高至1.0(20/20)。
眼底自发荧光(fundus autofluorescence,FAF)图像未见明显视网膜损伤。






图5 眼底照片(A)显示右眼黄斑区视网膜神经上皮层浆液性脱离及色素改变;眼底荧光血管造影(B)显示右眼黄斑中心凹附近的局灶性渗漏

图6 OCT图片显示黄斑区SRF伴细小的灰白色视网膜下沉淀物,以及粗糙的RPE层
图7 OCT图片显示PDT术后1个月(A)、3个月(B)和6个月(C)随访中黄斑区持续的SRF

图8 OCT图片显示SMLP术后1个月(A)、3个月(B)和6个月(C)随访中的黄斑区,图像表明SRF在术后3个月和6个月完全吸收

图9 在SMLP术后1个月(A),3个月(B)和6个月(C)微视野检查显示右眼黄斑敏感性持续改进
1.2.2 病例讨论
CSC是一种较年轻成年人常见的黄斑疾病,常由于视网膜神经上皮脱离和视网膜色素上皮损伤导致视力障碍[6]。传统的激光光凝治疗可缩短病程,加快SRF的吸收,然而这种治疗不适合用于黄斑中心凹附近的渗漏点[7]。到目前为止,半剂量光动力疗法是在渗漏点靠近黄斑中心凹的慢性CSC的一线治疗[8-9]。然而,就像该患者一样,如何治疗慢性CSC在PDT后持续的SRF仍然没有答案。Murphy教授和Olsen教授[10-11]认为:SMLP的出现丰富CSC的治疗选择。该患者的主治医生Jin教授认为该病例的经验表明SMLP是治疗CSC而无明显视网膜损伤的一种选择。SMLP是近年来激光治疗视网膜疾病的新型激光传输方式。Jin教授介绍,在微脉冲模式中,激光能量被分配为由开启时间或关闭时间组成的微脉冲。“开启”时间是每个脉
冲的持续时间,而“关闭”时间则是在连续微脉冲之间使热力降温的时间,这可以减少邻近组织的热损伤[12]。在这种情况下,通过SMLP治疗,持续SRF的患者在PDT术后得到了满意的解剖恢复且提高了视觉功能。总之,SMLP具有很多优点,如价格低廉,重复治疗,无明显视网膜损伤。它对于CSC行PDT术后持续SRF的治疗的可能是一个不错的选择[13],尤其是那些渗漏点位于中央凹附近的患者。
1.3 病例三
1.3.1 病例介绍
一位6岁的男孩患者,主诉左眼视力差1个多月而来到ZOC。男孩是通过剖腹产出生的足月婴儿,有地中海贫血病史,家人均体健。右眼矫正视力0.5(20/40),左眼无光感。右眼的眼内压为11 mmHg
(1 mmHg=0.133 kPa),左眼为14 mmHg。左眼瞳孔散大,直接对光反射消失,无眼球震颤、斜视(图10)。
双侧视盘肿大苍白(图11)。超声生物显微镜(ultrasound
biomicroscopy,UBM)显示双眼前房角开放;超声检查显示双眼正常眼轴长度;FFA显示早期和晚期无明显渗漏;OCT显示左侧黄斑视网膜神经层囊腔改变;ANGIO OCT显示双侧视盘血管不连续,且左眼可见狭窄的血管;视觉诱发电位(visual evoked potentia,VEP)显示右眼PVEP反应严重异常,左眼FVEP反应严重异常;视网膜电图(electroretinogram,ERG)表明,
右眼视杆细胞的反应正常,视锥细胞有轻微异常反应;左眼视杆细胞有轻微异常反应,视锥细胞有中度异常反应。此外,颅脑影像学检查的应用:MRI显示部分空蝶鞍,Galen静脉畸形、脉络膜裂囊肿;
神经高分辨率MRI显示视神经细小,嗅球、嗅裂、
嗅束发育不良。血液和尿液检查呈小细胞低色素性贫血,低FSH,LH,睾酮水平与尿蛋白阳性。男孩的模样很特别:深眼窝、方颅(图12);弯曲的左手食指和脚趾之间有宽间隙。




图10 双眼图片显示左眼瞳孔散大,直接对光反射消失(B)

图11 眼底照片显示双侧视盘扩大和苍白

图12 照片显示男孩的特殊外观:深眼窝、方颅
1.3.2 病例讨论
查房时,所有视网膜专家一致认为这是一个
非常具有挑战性的病例,初步诊断该病例为“视盘缺损合并视神经发育不全”和一些全身异常。该病例的主治医师Jie Hu教授解释:这个男孩的阳
性结果引起了我们的思考,是否该异常是一种可能的综合征(如Kallmann综合征或视隔发育不良等),或原发性视神经盘缺损合并视神经发育不良。以上各症状有一定的匹配点和差异点:Kallmann综合征也有嗅球、嗅裂、嗅束发育不良,以及促性腺激素水平降低[14]。然而,曾有报道[15]Kallmann综合征无眼部并发症,且这位男孩的嗅觉正常;视隔发育不良也会有视神经发育不全、内分泌失调和部分空蝶鞍。有趣的是,MRI没有发现透明隔发育不良的征象,而且只有性腺激素受影响。Chew教授、Murphy和Olsen教授均强调当遇到有视神经发育不全患者时,应该关注潜在可能的中枢神经系统和激素水平的异常。Chi-Chao Chan教授建议咨询美国国立卫生研究院、国立眼科研究所的眼部缺损专家Brian Brooks博士[16]。Brooks博士建议随访患者的肾功能,因为这些患者将有更大的机会患肾病。
1.4 病例四
1.4.1 病例介绍
一位26岁的女性自诉左眼视力下降数年,加重2周,遂来ZOC就诊。她的右眼在儿童时期就已经失明。没有眼科病史或家族史。检查时发现右眼(right eye,OD)视力无光感,而左眼(left eye,OS)视力0.1(20/200)。眼压分别是:右眼10 mmHg和左
眼12.3 mmHg。右眼存在小角膜和角膜白斑。左眼异常包括下方虹膜缺损,白内障合并晶状体下部凹痕和睫状小带断裂(图13),视神经萎缩和下方脉络膜缺损(图14)。左眼B超显示RD。行左眼23G经睫状体平坦部晶状体切除术、玻璃体切除术、视网膜
切开、重水、眼内激光、周边虹膜切除术、气液交换和硅油填充术。术中未发现视网膜裂孔。在随访末期(术后第2周),视网膜保持良好复位。



图13 眼前段照片显示左眼白内障(白色箭头)与明显的晶状体下部凹痕(蓝色箭头)和虹膜缺损(红色箭头)

图14 左眼的眼底照片显示视盘萎缩(黄色箭头),下方脉络膜缺损(白色箭头)和视网膜脱离(蓝色箭头)
1.4.2 病例讨论
先天性虹膜晶状体脉络膜缺损是一种罕见的疾病,由眼部发育时视裂关闭失败所引起[17]。本病例是一个典型的缺损,包括下方象限的虹膜、
脉络膜和视网膜缺损。手术治疗以处理其并发的白内障和RD是必要的[18]。专家们对该病例手术方式的选择进行了讨论。玻璃体切除术被推荐为首选[19]。Olsen教授建议手术中应该仔细地在视盘和眼缺损处解除玻璃体牵引,仔细搜索视网膜裂孔,并在缺损边缘行眼内激光。周边虹膜切开术并不推荐,因为已存在下方的虹膜缺损。ZOC眼底病中心主任、玻璃体手术专家Lin Lu教授认为:只有当晶状体混浊妨碍玻璃体切除术进行才需行白内障手术。该例患者可以采用硅油填充,但是由于本例中存在视盘萎缩,应该注意硅油在经视神经管内移位的可能。考虑到视网膜与缺损组织边缘粘连的困难,硅油眼内填充时间推荐为3~6个月或更长的时间。
基金
暂无基金信息
参考文献
1. Lonser RR, Glenn GM, Walther M, et al. von HippelLindau disease[J]. Lancet 2003, 361(9374): 2059-2067.
2. Singh AD, Nouri M, Shields CL, et al. Treatment of retinal capillary hemangioma[J]. Ophthalmology, 2002, 109(10): 1799-1806.
3. Raja D, Benz MS, Murray TG, et al. Salvage external beam radiotherapy of retinal capillary hemangiomas secondary to von Hippel-Lindau disease: visual and anatomic outcomes[J]. Ophthalmology, 2004, 111(1): 150-153.
4. Gaudric A, Krivosic V, Duguid G, et al. Vitreoretinal surgery for severe retinal capillary hemangiomas in von hippel-lindau disease[J]. Ophthalmology, 2011, 118(1): 142-149.
5. Choyke PL, Glenn GM, Walther MM, et al. von Hippel-Lindau disease: genetic, clinical, and imaging features[J]. Radiology, 1995, 194(3): 629-642.
6. Daruich A, Matet A, Dirani A, et al. Central serous chorioretinopathy: Recent fndings and new physiopathology hypothesis[J]. Prog Retin Eye Res, 2015, 48: 82-118.
7. Nicholson B, Noble J, Forooghian F, et al. Central serous chorioretinopathy: update on pathophysiology and treatment[J]. Surv Ophthalmol, 2013, 58(2): 103-126.
8. Zhao M, Zhang F, Chen Y, et al. A 50% vs 30% dose of verteporfn (photodynamic therapy) for acute central serous chorioretinopathy: one-year results of a randomized clinical trial[J]. JAMA Ophthalmol, 2015, 133(3): 333-340.
9. Chan WM, Lai TY, Lai RY, et al. Half-dose verteporfn photodynamic therapy for acute central serous chorioretinopathy: one-year results of a randomized controlled trial[J]. Ophthalmology, 2008, 115(10): 1756-1765.
10. Sivaprasad S, Elagouz M, McHugh D, et al. Micropulsed diode laser therapy: evolution and clinical applications[J]. Surv Ophthalmol, 2010, 55(6): 516-530.
11. Abd Elhamid AH. Subthreshold micropulse yellow laser treatment for nonresolving central serous chorioretinopathy[J]. Clin Ophthalmol, 2015, 9: 2277-2283.
12. D o r i n G . S u b t h r e s h o l d a n d m i c r o p u ls e d i o d e l a s e r photocoagulation[J]. Semin Ophthalmol, 2003, 18(3): 147-153.
13. Scholz P, Ersoy L, Boon CJ, et al. Subthreshold micropulse laser (577 nm) treatment in chronic central serous chorioretinopathy[J]. Ophthalmologica, 2015, 234(4): 189-194.
14. Kim SH. Congenital hypogonadotropic hypogonadism and kallmann syndrome: past, present, and future[J]. Endocrinol Metab (Seoul) 2015, 30(4): 456-466.
15. Webb EA, Dattani MT. Septo-optic dysplasia. Eur J Hum Genet, 2010, 18(3): 393-397.
16. Huynh N, Blain D, Glaser T, et al. Systemic diagnostic testing in patients with apparently isolated uveal coloboma[J]. Am J Ophthalmol, 2013, 156(6): 1159-1168.
17. Stoll C, Alembik Y, Dott B, et al. Epidemiology of congenital eye malformations in 131,760 consecutive births[J]. Ophthalmic Paediatr Genet, 1992, 13(3): 179-186.
18. Ramezani A, Dehghan MH, Rostami A, et al. Outcomes of retinal detachment surgery in eyes with chorioretinal coloboma[J]. J Ophthalmic Vis Res, 2010, 5(4): 240-245.
19. Vukovic D, Pajic SP, Paovic P. Retinal detachment in the eye with the choroidal coloboma[J]. Srp Arh Celok Lek, 2014, 142(11/12): 717-720.